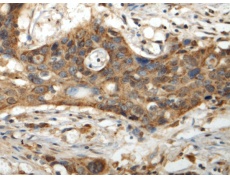
一抗

中文名稱: 兔抗IQCC多克隆抗體
英文名稱: Anti-IQCC rabbit polyclonal antibody
技術(shù)規(guī)格
|
Background: |
The function of this protein remains unknown. |
|
Applications: |
ELISA, WB, IHC |
|
Name of antibody: |
IQCC |
|
Immunogen: |
Fusion protein of human IQCC |
|
Full name: |
IQ motif containing C |
|
SwissProt: |
Q4KMZ1 |
|
ELISA Recommended dilution: |
5000-10000 |
|
IHC positive control: |
Human esophagus cancer |
|
IHC Recommend dilution: |
150-300 |
|
WB Predicted band size: |
53 kDa |
|
WB Positive control: |
LOVO cell lysate |
|
WB Recommended dilution: |
1000-5000 |


 購物車
購物車 幫助
幫助
 021-54845833/15800441009
021-54845833/15800441009